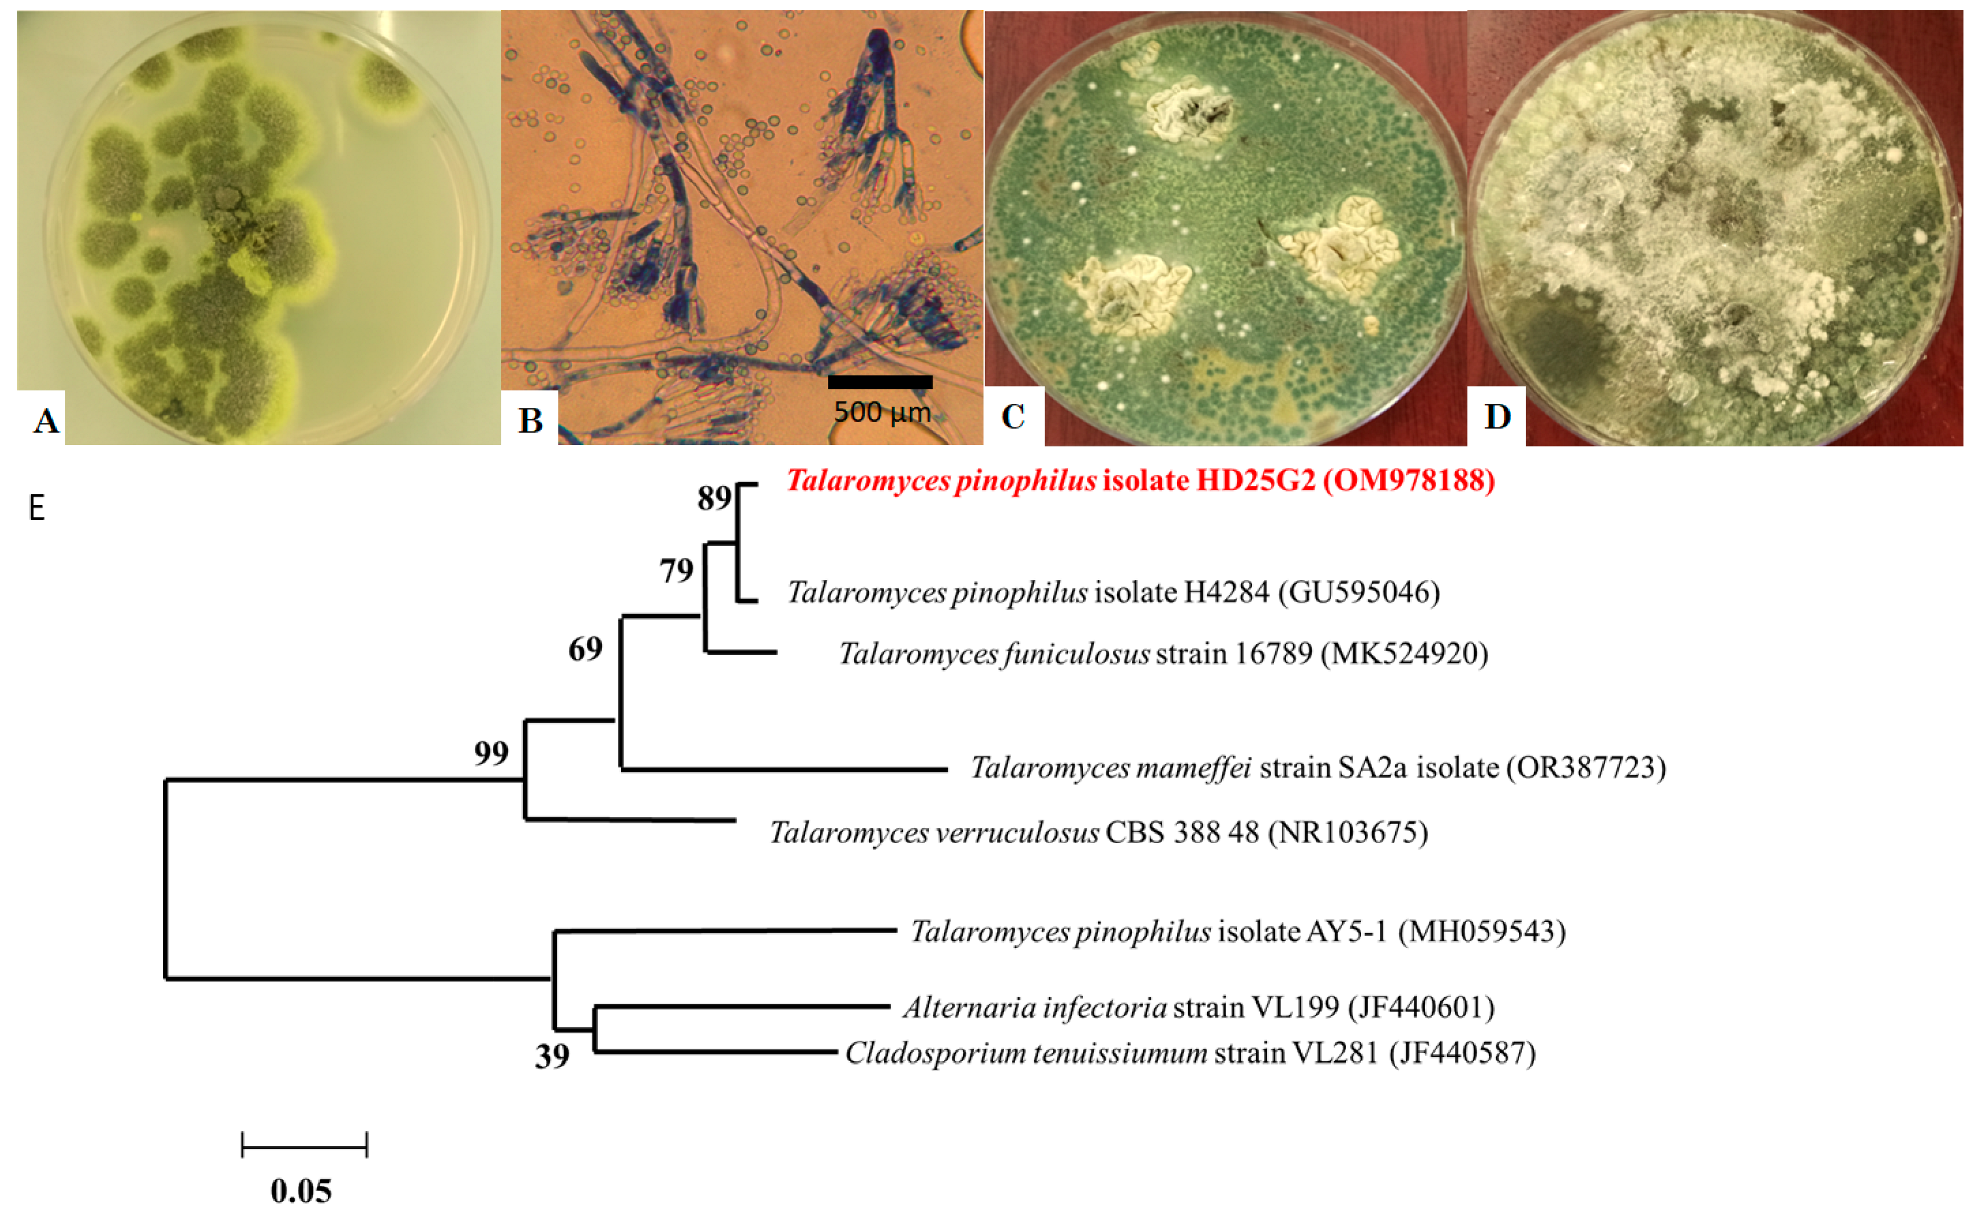
Jof 11 00588 g002 Jof 11 00588 g002

Talaromyces pinophilus Strain HD25G2 as a Novel Biocontrol Agent of Fusarium culmorum, the Causal Agent of Root and Crown Rot of Soft Wheat
Abstract
1. Introduction
2. Materials and Methods
2.1. Fungal Isolation and Identification
2.2. Molecular Identification of Talaromyces spp. and Fusarium spp. Strains by PCR Assay
2.3. Antagonistic Activity
2.3.1. Dual Culture Test
2.3.2. Talaromyces pinophilus Culture Filtrate Inhibition Test
2.4. Direct Confrontation Test
2.5. Mycotoxin Production
2.6. Enzymes Qualitative Screening of T. pinophilus HD25G2
- Clear zones around the disc indicate proteolytic activity.
- The chitin hydrolysis area changes colour from yellow to purple.
- The presence of a yellow opaque zone surrounding the colonies shows the presence of cellulases.
2.7. Quantitative Enzyme Assays
2.7.1. Determination of Protease Activity
2.7.2. Chitinase Hydrolytic Activity Assay
2.8. Statistical Analysis
3. Results
3.1. Fungal Isolation and Identification
3.2. Mycelial Growth Inhibition
3.3. Mycotoxin Analysis
3.4. T. pinophilus Extracellular Enzymes
4. Discussion
5. Conclusions
Author Contributions
Funding
Institutional Review Board Statement
Informed Consent Statement
Data Availability Statement
Acknowledgments
Conflicts of Interest
References
- Gai, Y.; Wang, H. Plant Disease: A Growing Threat to Global Food Security. Agronomy 2024, 14, 1615. [Google Scholar] [CrossRef]
- Ekwomadu, T.I.; Mwanza, M. Fusarium Fungi Pathogens, Identification, Adverse Effects, Disease Management, and Global Food Security: A Review of the Latest Research. Agriculture 2023, 13, 1810. [Google Scholar] [CrossRef]
- Mielniczuk, E.; Skwaryło-Bednarz, B. Fusarium Head Blight, Mycotoxins and Strategies for Their Reduction. Agronomy 2020, 10, 509. [Google Scholar] [CrossRef]
- Ferrigo, D.; Raiola, A.; Causin, R. Fusarium Toxins in Cereals: Occurrence, Legislation, Factors Promoting the Appearance and Their Management. Molecules 2016, 21, 627. [Google Scholar] [CrossRef]
- Paulitz, T.C.; Schroeder, K.L.; Schillinger, W.F. Soilborne pathogens of cereals in an irrigated cropping system: Effect of tillage, residue management, and crop rotation. Plant Dis. 2010, 94, 61–66. [Google Scholar] [CrossRef]
- Abdallah-Nekache, N.; Laraba, I.; Ducos, C.; Barreau, C.C.; Bouznad, Z.; Bouregheda, H. Occurrence of Fusarium head blight and Fusarium crown rot in Algerian wheat: Identification of associated species and assessment of aggressiveness. Eur. J. Plant Pathol. 2019, 154, 499–512. [Google Scholar] [CrossRef]
- Smiley, R.W.; Gourlie, J.A.; Easley, S.A.; Patterson, L.-M.; Whittaker, R.G. Pathogenicity of fungi associated with the wheat crown complex in Oregon and Washington. Plant Dis. 2005, 89, 949–957. [Google Scholar] [CrossRef]
- Xu, X.; Nicholson, P. Community ecology of fungal pathogens causing wheat head blight. Annu. Rev. Phytopathol. 2009, 47, 83–103. [Google Scholar] [CrossRef] [PubMed]
- Moya-Elizondo, E.A.; Arismendi, N.; Montalva, C.; Doussoulin, H. First Report of Fusarium sporotrichioides Causing Foliar Spots on Forage Corn in Chile. Plant Dis. 2013, 97, 1113. [Google Scholar] [CrossRef] [PubMed]
- Błaszczyk, L.; Ćwiek-Kupczyńska, H.; Hoppe Gromadzka, K.; Basińska-Barczak, A.; Stępień, Ł.; Kaczmarek, J.; Lenc, L. Containment of Fusarium culmorum and Its Mycotoxins in Various Biological Systems by Antagonistic Trichoderma and Clonostachys Strains. J. Fungi 2023, 9, 289. [Google Scholar] [CrossRef]
- Corkley, I.; Fraaije, B.; Hawkins, N. Fungicide resistance management: Maximizing the effective life of plant protection products. Plant Pathol. 2022, 71, 150–169. [Google Scholar] [CrossRef]
- Akrami, M.; Yousefi, Z. Biological Control of Fusarium wilt of Tomato (Solanum lycopersicum) by Trichoderma spp. as Antagonist Fungi. Biol. Forum 2015, 7, 887–892. [Google Scholar]
- Arie, T. Fusarium diseases of cultivated plants, control, diagnosis, and molecular and genetic studies. J. Pestic. Sci. 2019, 44, 275–281. [Google Scholar] [CrossRef]
- Berg, G.; Zachow, C.; Müller, H.; Philipps, J.; Tilcher, R. Next-Generation Bio-Products Sowing the Seeds of Success for Sustainable Agriculture. Agronomy 2013, 3, 648–656. [Google Scholar] [CrossRef]
- Yao, Y.Q.; Lan, F.; Qiao, Y.M.; Wei, J.G.; Huang, R.S.; Li, L.B. Endophytic fungi harbored in the root of Sophora tonkinensis Gapnep: Diversity and biocontrol potential against phytopathogens. Microbiol. Open 2017, 6, e00437. [Google Scholar] [CrossRef]
- Koul, M.; Meena, S.; Kumar, A.; Sharma, P.R.; Singamaneni, V.; Riyaz-Ul-Hassan, S.; Kong, W.L.; Rui, L.; Ni, H.; Wu, X.Q. Antifungal Effects of Volatile Organic Compounds Produced by Rahnella aquatilis JZ-GX1 Against Colletotrichum gloeosporioides in Liriodendron chinense × tulipifera. Front. Microbiol. 2020, 11, 1114. [Google Scholar] [CrossRef]
- Nicoletti, R.; Trincone, A. Bioactive compounds produced by strains of Penicillium and Talaromyces of marine origin. Mar. Drugs 2016, 14, 37. [Google Scholar] [CrossRef]
- Caro, Y.; Venkatachalam, M.; Lebeau, J.; Fouillaud, M.; Dufossé, L. Pigments and colorants from filamentous fungi. In Fungal Metabolites; Mérillon, J.-M., Ramawat, K.G., Eds.; Springer International Publishing: Cham, Switzerland, 2017; Volume 26, pp. 499–568. [Google Scholar]
- Alagesaboopathi, C. Biological control of damping-off disease of cotton seedling. Curr. Sci. 1994, 95, 865–868. [Google Scholar]
- Nicoletti, R.; De Stefano, M.; De Stefano, S.; Carella, A. Antagonism against Rhizoctonia solani and fungitoxic metabolite production by some Penicillium isolates. Mycopathologia 2004, 158, 465–474. [Google Scholar] [CrossRef] [PubMed]
- Abdel-Rahim, I.R.; Abo-Elyousr, K.A.M. Talaromyces pinophilus strain AUN-1 as a novel mycoparasite of Botrytis cinerea, the pathogen of onion scape and umbel blights. Microbiol. Res. 2018, 213, 1–9. [Google Scholar] [CrossRef] [PubMed]
- Yang, H.; Cui, S.; Wei, Y.; Li, H.; Hu, J.; Yang, K.; Wu, Y.; Zhao, Z.; Li, J.; Wang, Y.; et al. Antagonistic effects of Talaromyces muroii TM28 against Fusarium crown rot of wheat caused by Fusarium pseudograminearum. Front. Microbiol. 2004, 14, 1292885. [Google Scholar] [CrossRef]
- Koul, M.; Meena, S.; Kumar, A.; Sharma, P.R.; Singamaneni, V.; Riyaz-Ul-Hassan, S.; Hamid, A.; Chaubey, A.; Prabhakar, A.; Gupta, P. Secondary metabolites from endophytic fungus Penicillium pinophilum induce ROS-mediated apoptosis through mitochondrial pathway in pancreatic cancer cells. Planta Medica 2016, 82, 344–355. [Google Scholar] [CrossRef]
- Abdel-Hafez, S.I.I.; Abo-Elyousr, K.A.; Abdel-Rahim, I.R. Leaf surface and endophytic fungi associated with onion leaves and their antagonistic activity against Alternaria porri. Czech Myco. 2015, 67, 1–22. [Google Scholar] [CrossRef]
- Chabasse, D.; Bouchara, J.P.; de Gentile, L.; Brun, S.; Cimon, B.; Penn, P. Les moisissures d’intérêt médical. Cahier de formation biologie médicale. In Cahier de Formation Bioforma, 1st ed.; Beddosa, A., Ed.; Bioforma: Paris, France, 2002; Volume 25, pp. 26–45. [Google Scholar]
- Leslie, J.F.; Summerell, B.A. The Fusarium Laboratory Manual; Blackwell Publishing: Oxford, UK, 2006; p. 109. [Google Scholar]
- Gardes, M.; Bruns, T.D. ITS primers with enhanced specificity for basidiomycetes—Application to the identification of mycorrhizae and rusts. Mol. Ecol. 1993, 2, 113–118. [Google Scholar] [CrossRef]
- Da Cruz Cabral, L.; Delgado, J.; Patriarca, A.; Rodríguez, A. Differential response to synthetic and natural antifungals by Alternaria tenuissima in wheat simulating media: Growth, mycotoxin production and expression of a gene related to cell wall integrity. Int. J. Food Microbiol. 2019, 292, 48–55. [Google Scholar] [CrossRef] [PubMed]
- Islam, M.M.; Hossain, D.M.; Rahman, M.M.E.; Suzuki, K.; Narisawa, T.; Hossain, I.; Harada, N. Native Trichoderma strains isolated from Bangladesh with broad spectrum antifungal action against fungal phytopathogens. Arch. Phytopathol. Plant Prot. 2016, 49, 75–93. [Google Scholar] [CrossRef]
- Marques, E.; Martins, I.; Mello, S.C.M. Antifungal potential of crude extracts of Trichoderma spp. Biota Neotrop. 2017, 18, e20170418. [Google Scholar]
- Galán, A.J.; Ruiz-Moyano, S.; Martín, A.; Delgado, J.; Álvarez, M.; López-Corrales, M. Implementation of netting system for production of ‘Calabacita’ dried figs: Effects on pest incidence, fruit quality and mycotoxin occurrence. Sci. Hortic. 2024, 331, 113099. [Google Scholar] [CrossRef]
- Cherukupally, R.; Amballa, H.; Reddy, B.N. In vitro screening for enzymatic activity of Trichoderma species for biocontrol potential. Ann. Plant Sci. 2017, 6, 1784–1789. [Google Scholar] [CrossRef]
- Reghmit, A.; Benzina-tihar, F.; Halouane-Sahir, F.; Oukali, Z.; Ghozali, N. Trichoderma spp. isolates from the rhizosphere of healthy olive trees in northern Algeria and their biocontrol potentials against the olive wilt pathogen, Verticillium dahlia. Org. Agric. 2021, 11, 639–657. [Google Scholar] [CrossRef]
- Burcham, D.C.; Abarrientos, J.R.; Wong, J.Y.; Ali, M.I.M.; Fong, Y.K.; Schwarze, F.W. Field evaluation of Trichoderma spp. as a biological control agent to preventwood decay on Benin mahogany (Khaya grandifoliola) and rain tree (Samanea saman) in Singapore. Biol. Control 2017, 114, 114–124. [Google Scholar] [CrossRef]
- Gotor-Vila, A.; Usall, J.; Torres, R.; Abadias, M.; Teixidó, N. Formulation of the biocontrol agent Bacillus amyloliquefaciens CPA-8 using different approaches: Liquid, freeze- drying and fluid-bed spray-drying. Biol. Control 2017, 62, 545–555. [Google Scholar] [CrossRef]
- Jalgaonwala, R.E.; Mohite, B.V.; Mahajan, R.T. A review: Natural products from plant associated endophytic fungi. J. Microbiol. Biotech. Res. 2017, 1, 21–32. [Google Scholar]
- Zandyavari, N.; Sulaiman, M.A.; Hassanzadeh, N. Molecular characterization and biocontrol potential of Trichoderma spp. against Fusarium oxysporum f. sp. dianthi in carnation. Egypt. J. Biol. Pest Control 2024, 34, 1. [Google Scholar] [CrossRef]
- Dethoup, T.; Kaewsalong, N.; Songkumorn, P.; Jantasorn, A. Potential application of a marine-derived fungus, Talaromyces tratensis KUFA 0091 against rice diseases. Bio. Control 2017, 119, 1–6. [Google Scholar] [CrossRef]
- Naraghi, L.; Heydari, A.; Rezaee, S.; Razavi, M.; Jahanifar, H. Study on antagonistic effects of Talaromyces flavus on Verticillium albo-atrum, the causal agent of potato wilt disease. Crop Prot. 2010, 29, 658–662. [Google Scholar] [CrossRef]
- Tian, Y.H.; Peng, H.Y.; Wang, D.H.; Li, X.F.; He, B.L.; Gao, K.X. Biocontrol potential of Talaromyces purpurogenus and its regulation on soil microbial community. J. App. Ecol. 2020, 31, 3255–3266. [Google Scholar]
- Bouanaka, H.; Bellil, I.; Khelifi, D. Multiple methods for varietal resistance assessment of durum wheat cultivars against Fusarium culmorum the causal agent of Fusarium head blight and crown rot in Algeria. Physiol. Mol. Plant Pathol. 2021, 115, 101683. [Google Scholar] [CrossRef]
- Houbraken, J.; de Vries, R.P.; Samson, R.A. Modern taxonomy of biotechnologically important Aspergillus and Penicillium species. In Advances in Applied Microbiology; Gadd, G.M., Sariaslani, S., Eds.; Academic Press: Cambridge, MA, USA, 2013; pp. 119–249. [Google Scholar]
- Fujii, T.; Hoshino, T.; Inoue, H.; Yano, S. Taxonomic revision of the cellulose degrading fungus Acremonium cellulolyticus nomen nudum to Talaromyces based on phylogenetic analysis. FEMS Microbiol. Lett. 2014, 351, 32–41. [Google Scholar] [CrossRef]
- Haggag, W.M.; Kansoh, A.L.; Aly, A.M. Proteases from Talaromyces flavus and Trichoderma harzianum: Purification, Characterisation and Antifungal Activity Against Brown Spot Disease on Faba Bean. Plant Pathol. Bull. 2006, 15, 231–239. [Google Scholar]
- Wang, B.; Guo, L.; Ye, K.; Wang, L. Chromosome-scale genome assembly of Talaromyces rugulosus W13939, a mycoparasitic fungus and promising biocontrol agent. Mol. Plant-Microbe Interact. 2020, 33, 1446–1450. [Google Scholar] [CrossRef]
- Aggarwal, S.; Dorairaj, S.; Adlakha, N. Stoichiometric balance ratio of cellobiose and gentiobiose induces cellulase production in Talaromyces cellulolyticus. Biotechnol. Biofuels Bioprod. 2023, 16, 48. [Google Scholar] [CrossRef]
- Kim, K.S.; Lee, Y.H. Gene expression profiling during conidiation in the rice blast pathogen Magnaporthe oryzae. PLoS ONE 2012, 7, e43202. [Google Scholar] [CrossRef]
- Karthik, C.; Elangovan, N.; Kumar, T.S.; Govindharaju, S.; Barathi, S.; Oves, M. Characterization of multifarious plant growth promoting traits of rhizobacterial strain AR6 under chromium (VI) stress. Microbiol. Res. 2017, 204, 65–71. [Google Scholar] [CrossRef]
- Li, D.; Chen, S.; Jing, L. Purification and partial characterization of two chitinases from the mycoparasitic fungus Talaromyces flavus. Mycopathologia 2005, 159, 223–229. [Google Scholar] [CrossRef]
- Plaza, V.; Silva-Moreno, E.; Castillo, L. Breakpoint: Cell wall and glycoproteins and their crucial role in the phytopathogenic fungi infection. Curr. Prot. Peptid. Sci. 2020, 21, 227–244. [Google Scholar] [CrossRef] [PubMed]
- Lenardon, M.D.; Munro, C.A.; Gow, N.A.R. Chitin synthesis and fungal pathogenesis. Curr. Opin. Microbiol. 2010, 13, 416–423. [Google Scholar] [CrossRef] [PubMed]
- Benhamou, N.; Chet, I. Hyphal interactions between Trichoderma harzianum and Rhizoctonia solani: Ultrastructure and gold cytochemistry of the mycoparasitic process. Phytopathology 1993, 83, 1062–1071. [Google Scholar] [CrossRef]
- Ting, A.S.Y.; Chai, J.Y. Chitinase and β-1, 3-glucanase activities of Trichoderma harzianum in response towards pathogenic and non-pathogenic isolates: Early indications of compatibility in consortium. Biocatal. Agric. Biotechnol. 2015, 4, 109–113. [Google Scholar] [CrossRef]
- Pandey, V.; Shukla, A.; Kumar, J. Physiological and molecular signalling involved in disease management through Trichoderma: An effective biocontrol paradigm. In Current Trends in Plant Disease Diagnostics and Management Practices; Kumar, P., Gupta, V.K., Tiwari, A.K., Kamle, M., Eds.; Springer International Publisher: Cham, Switzerland, 2016; Volume 12, pp. 317–346. [Google Scholar]
- Delgado, J.; Ballester, A.-R.; González-Candelas, L.; Núñez, F. Impact of the antifungal protein PgAFP on the proteome and patulin production of Penicillium expansum on apple-based medium. Int. J. Food Microbiol. 2022, 363, 109511. [Google Scholar] [CrossRef]
- Reghmit, A.; Benzina-tihar, F.; Sahir-Halouane, F. Volatile organic compounds activities of Trichoderma species isolated from olive grove soil against the wilt pathogen, Verticillium dahlia. Eur. J. Plant Pathol. 2024, 168, 15. [Google Scholar]
- Delgado, J.; Ballester, A.-R.; Núñez, F.; González-Candelas, L. Evaluation of the activity of the antifungal PgAFP protein and its producer mould against Penicillium spp postharvest pathogens of citrus and pome fruits. Food Microbiol. 2019, 84, 103266. [Google Scholar] [CrossRef]
- Álvarez, M.; Rodríguez, A.; Núñez, F.; Silva, A.; Andrade, M.I. In vitro antifungal effects of spices on ochratoxin A production and related gene expression in Penicillium nordicum on a dry-cured fermented sausage medium. Food Control 2020, 114, 107222. [Google Scholar] [CrossRef]
- Peromingo, B.; Sulyok, M.; Lemmens, M.; Rodríguez, A.; Rodríguez, M. Diffusion of mycotoxins and secondary metabolites in dry-cured meat products. Food Control 2019, 101, 144–150. [Google Scholar] [CrossRef]
- Cebrián, E.; Rodríguez, M.; Peromingo, B.; Bermúdez, E.; Núñez, F. Efficacy of the combined protective cultures of Penicillium chrysogenum and Debaryomyces hansenii for the control of ochratoxin a hazard in dry-cured ham. Toxins 2019, 11, 710. [Google Scholar] [CrossRef] [PubMed]
- Cebrián, E.; Núñez, F.; Gálvez, F.J.; Delgado, J.; Bermúdez, E.; Rodríguez, M. Selection and Evaluation of Staphylococcus xylosus as a Biocontrol Agent against Toxigenic Moulds in a Dry-Cured Ham Model System. Microorganisms 2020, 8, 793. [Google Scholar] [CrossRef]
- Schmidt-Heydt, M.; Baxter, E.; Geisen, R.; Magan, N. Physiological relationship between food preservatives, environmental factors, ochratoxin and otapksPV gene expression by Penicillium verrucosum. Int. J. Food Microbiol. 2007, 3, 277–283. [Google Scholar] [CrossRef]
- Álvarez, M.; Agostini, I.; Silva, S.; Dallemole-Giaretta, R.; Sulyok, M.; Sampaio, A.; Rodrigues, P. Mycotoxins and Other Secondary Metabolites Are Produced by Gnomoniopsis smithogilvyi When Confronted with Biological and Chemical Control Agents. Agriculture 2023, 13, 1166. [Google Scholar] [CrossRef]

| Media | Assay | Percentage of Growth Inhibition of F. culmorum (%) |
|---|---|---|
| Potato dextrose agar | Dual culture | 72.59 ± 0.37 *a |
| Filtrate culture | 61.48 ± 0.74 *a | |
| Soft wheat simulating media aw 0.98 | Dual culture | 73.7 ± 0.37 *a |
| Filtrate culture | 62.96 ± 3.70 *a | |
| Soft wheat simulating media aw 0.95 | Dual culture | 72.22 ± 2.12 *a |
| Filtrate culture | 59.99 ± 1.03 *a |
| Water Activity (aw) | Treatment | Zearalenone (ng/g) |
|---|---|---|
| 0.98 | Control | 0.63 ± 0.84 a |
| F. culmorum + T. pinophilus | 104.19 ± 60.98 b | |
| 0.95 | Control | 8.33 ± 6.99 c |
| F. culmorum + T. pinophilus | 334.16 ± 17.76 d |
Disclaimer/Publisher’s Note: The statements, opinions and data contained in all publications are solely those of the individual author(s) and contributor(s) and not of MDPI and/or the editor(s). MDPI and/or the editor(s) disclaim responsibility for any injury to people or property resulting from any ideas, methods, instructions or products referred to in the content. |
© 2025 by the authors. Licensee MDPI, Basel, Switzerland. This article is an open access article distributed under the terms and conditions of the Creative Commons Attribution (CC BY) license (https://creativecommons.org/licenses/by/4.0/).
Share and Cite
Bennacer, A.; Sahir-Halouane, F.; Alvarez, M.; Oukali, Z.; Bennacer, N.E.H.; Foughalia, A.; Delgado, J. Talaromyces pinophilus Strain HD25G2 as a Novel Biocontrol Agent of Fusarium culmorum, the Causal Agent of Root and Crown Rot of Soft Wheat. J. Fungi 2025, 11, 588. https://doi.org/10.3390/jof11080588
Bennacer A, Sahir-Halouane F, Alvarez M, Oukali Z, Bennacer NEH, Foughalia A, Delgado J. Talaromyces pinophilus Strain HD25G2 as a Novel Biocontrol Agent of Fusarium culmorum, the Causal Agent of Root and Crown Rot of Soft Wheat. Journal of Fungi. 2025; 11(8):588. https://doi.org/10.3390/jof11080588
Chicago/Turabian StyleBennacer, Amel, Fatma Sahir-Halouane, Micaela Alvarez, Zahia Oukali, Nour El Houda Bennacer, Abdelhamid Foughalia, and Josué Delgado. 2025. "Talaromyces pinophilus Strain HD25G2 as a Novel Biocontrol Agent of Fusarium culmorum, the Causal Agent of Root and Crown Rot of Soft Wheat" Journal of Fungi 11, no. 8: 588. https://doi.org/10.3390/jof11080588
APA StyleBennacer, A., Sahir-Halouane, F., Alvarez, M., Oukali, Z., Bennacer, N. E. H., Foughalia, A., & Delgado, J. (2025). Talaromyces pinophilus Strain HD25G2 as a Novel Biocontrol Agent of Fusarium culmorum, the Causal Agent of Root and Crown Rot of Soft Wheat. Journal of Fungi, 11(8), 588. https://doi.org/10.3390/jof11080588







